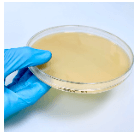
Tryptic Soy Agar + Neutralizing - For Microbiology Lab Testing
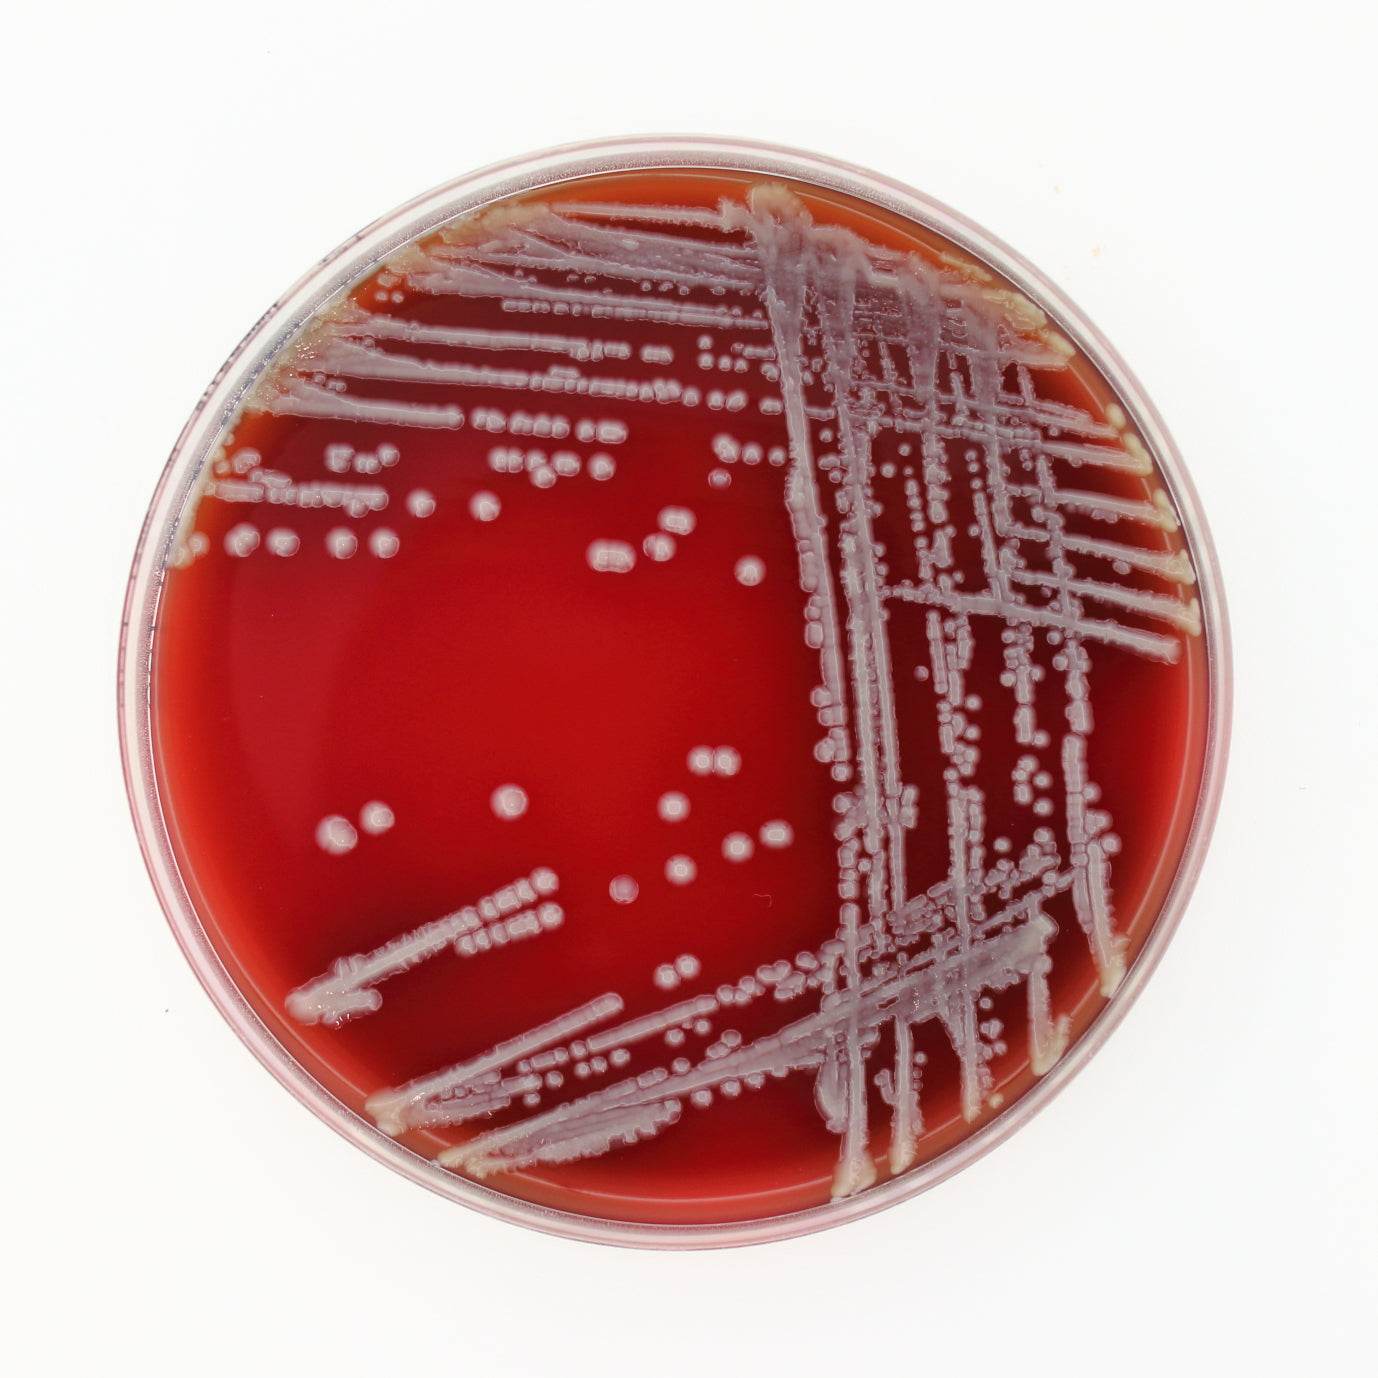
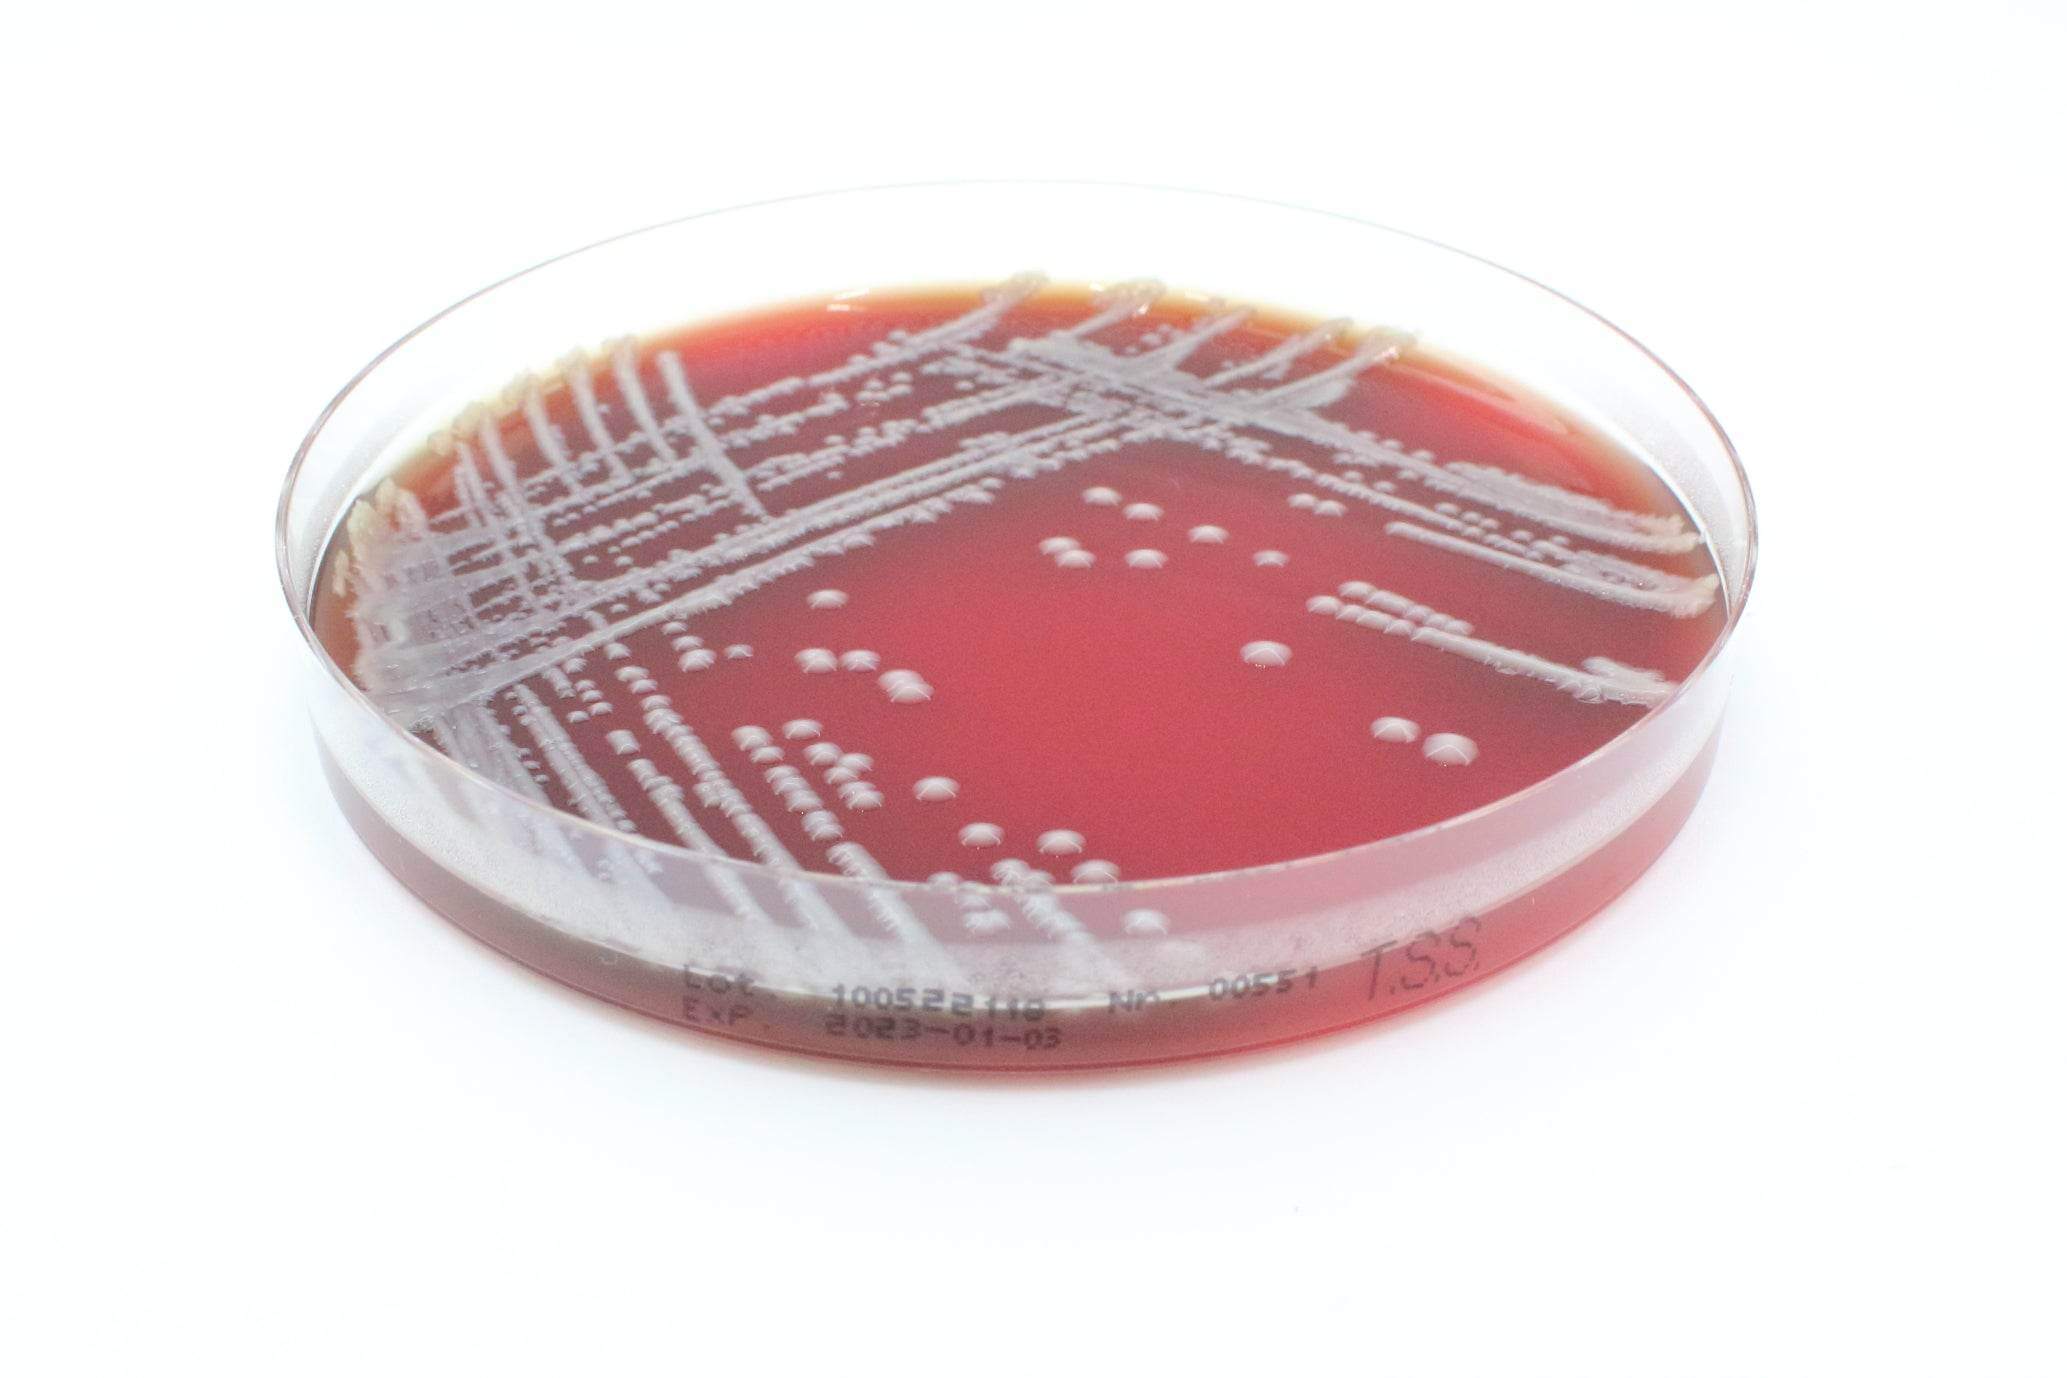
Tryptic Soy Agar (Sheep Blood 5%) - Kormay Biomedicals store

Microbiology Media & AST
Shop Microbiology Media & AST products for clinical diagnostics, food safety, and research, including antibiotic discs and culture media.
Showing 889 - 912 of 996 products
Display
View


Liofilchem
AST Antibiotec Sensitivity DISC Trimethoprim TM 2.5 µg - Microbiology Testing Disc (lab use only)
Sale priceFrom $68.00 CAD


Liofilchem
AST Antibiotec Sensitivity DISC Trimethoprim TM 5 µg - Microbiology Testing Disc (lab use only)
Sale priceFrom $119.00 CAD

Liofilchem
Tryptic Soy Agar + 0,1% Penase + Neutralizing - For Microbiology Lab Testing
Sale price$140.00 CAD

Liofilchem
Tryptic Soy Agar + 5% Penase + Neutralizing - For Microbiology Lab Testing
Sale price$311.00 CAD

Liofilchem
Tryptic Soy Agar + Lactamator 500 IU (Irradiated) - For Microbiology Lab Testing
Sale price$252.00 CAD


Liofilchem
Tryptic Soy Agar+Neutralizing Irradiated 30 mL - For Microbiology Lab Testing
Sale price$288.00 CAD

Liofilchem
Tryptic Soy Agar+Neutralizing Irradiated - For Microbiology Lab Testing
Sale price$119.00 CAD
Filters (0)